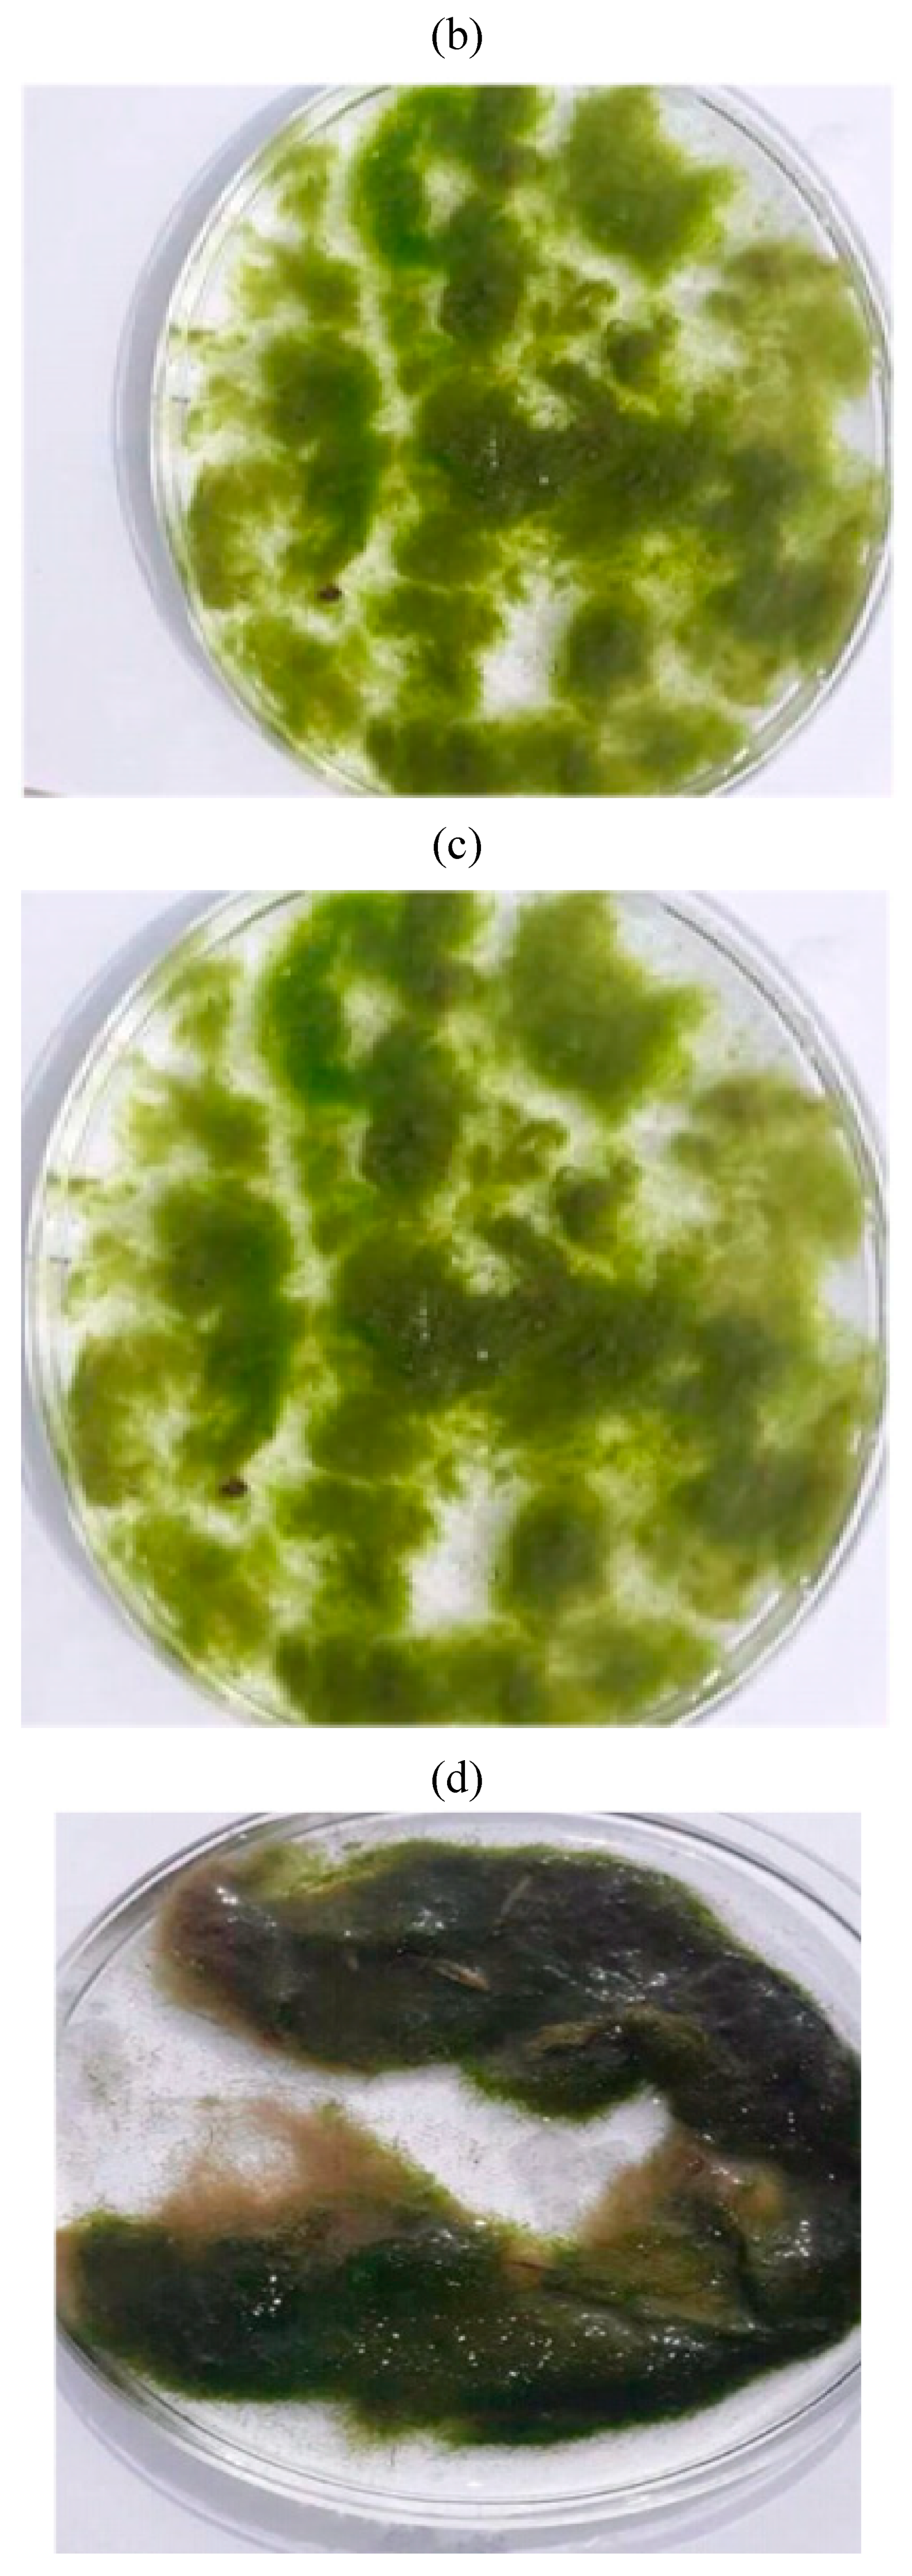
Water 15 00974 g002b Water 15 00974 g002b

Analysis of Heavy Metal Contamination in Macroalgae from Surface Waters in Djelfa, Algeria
Abstract
1. Introduction
2. Materials and Methods
2.1. Study Area
2.2. Hydrology
2.3. Climate
- ➢
- Site 01: the lake of Dar El Chioukh.
- ➢
- Site 02: Oued Mellah.
- ➢
- Site 03: Oued Boucedira (Figure 1).
2.4. Algae Sample Collection and Identification
2.5. Mineralization
2.6. Selection of Contaminants
2.7. Statistical Data Processing Techniques
3. Results and Discussion
- ➢
- Case of Cu
- ➢
- Case of Zn
- ➢
- Case of Fe
- ➢
- Case of Pb
3.1. PCA Analysis
- -
- Group 1: Spirogyra 1, Spirogyra 2, and Cladophora 3 with Fe
- -
- Group 2: Zygnema 2, Zygnema 3 with Pb.
- -
- Group 3: Zygnema 1, Chara 2, Chara 3, and Cladophora 2 with Zn.
- -
- Group 4: Cladophora 1, Spirogyra 3, and Chara 1 with Cu.
3.2. Principal Component Analysis (PCA)
4. Conclusions
- -
- The high bioaccumulation abilities of Cladophora, Spirogyra, Chara, and Zygnema algae for selected metals have been confirmed.
- -
- The results indicate that some species may serve as better biomonitors than others for certain elements. Based on the agreement with the available literature, we suggest Cladophora for Fe and Zn, Chara for Pb, and Spirogyra for Cu.
- -
- Interestingly, algae could serve as a good bio-indicator for pollution. The dispersal of heavy metals and their increased levels indicate the need for the government to monitor water of those sites more effectively and create public awareness of heavy metal accumulation in food.
- -
- In the three sites of the city of Djelfa, the levels of Fe and Pb in the four species of algae exceed the IAEA standard (497 mg/kg and 0.574 mg/kg, respectively). The levels of Cu also exceed the standard (23, 2 mg/kg) in the four species for site 1, in Chara and Zygnema for site 2, and in Chara and Spirogyra for site 3, whereas the levels of Zn remain low and are significantly lower than the standard.
- -
- Our findings on the amounts of Cu and Zn show the significance of these two metals to the biological processes. We have prioritized the accumulation rates of the four examined metals throughout this investigation. For the three sites, the metal accumulation gradient is as follows: Fe > Cu > Pb > Zn.
Author Contributions
Funding
Institutional Review Board Statement
Informed Consent Statement
Data Availability Statement
Acknowledgments
Conflicts of Interest
References
- Afroz, R.; Rahman, A. Health Impact of River Water Pollution in Malaysia. Int. J. Adv. Appl. Sci. 2017, 4, 78–85. [Google Scholar] [CrossRef]
- Jaishankar, M.; Tseten, T.; Anbalagan, N.; Mathew, B.; Beeregowda, K. Toxicity, Mechanism and Health Effects of Some Heavy Metals. Interdiscip. Toxicol. 2014, 7, 60–72. [Google Scholar] [CrossRef]
- Pan, L.; Fang, G.; Wang, Y.; Wang, L.; Su, B.; Li, D.; Xiang, B. Potentially Toxic Element Pollution Levels and Risk Assessment of Soils and Sediments in the Upstream River, Miyun Reservoir, China. Int. J. Environ. Res. Public. Health 2018, 15, 2364. [Google Scholar] [CrossRef]
- Odobašić, A.; Šestan, I.; Begić, S. Biosensors for Determination of Heavy Metals in Waters. In Biosensors for Environmental Monitoring; BoD—Books on Demand: Paris, France, 2019. [Google Scholar]
- Kacholi, D.S.; Sahu, M. Levels and Health Risk Assessment of Heavy Metals in Soil, Water, and Vegetables of Dar Es Salaam, Tanzania. J. Chem. 2018, 2018, 1402674. [Google Scholar] [CrossRef]
- Krishnamurti, G.; Subashchandrabose, S.; Mallavarapu, M.; Naidu, R. Assessment of Bioavailability of Heavy Metal Pollutants Using Soil Isolates of Chlorella Sp. Environ. Sci. Pollut. Res. Int. 2013, 22, 8826–8832. [Google Scholar] [CrossRef]
- Maltsev, Y.; Maltseva, A.; Maltseva, S. Differential Zn and Mn Sensitivity of Microalgae Species from Genera Bracteacoccus and Lobosphaera. Environ. Sci. Pollut. Res. 2021, 28, 1–12. [Google Scholar] [CrossRef] [PubMed]
- Shekhovtseva, O.; Maltseva, I. Physical, Chemical, and Biological Properties of Soils in the City of Mariupol, Ukraine. Eurasian Soil Sci. 2015, 48, 1393–1400. [Google Scholar] [CrossRef]
- Zamani-Ahmadmahmoodi, R.; Malekabadi, M.; Rahimi, R.; Johari, S.A. Aquatic Pollution Caused by Mercury, Lead, and Cadmium Affects Cell Growth and Pigment Content of Marine Microalga, Nannochloropsis Oculata. Environ. Monit. Assess. 2020, 192, 330. [Google Scholar] [CrossRef] [PubMed]
- Marinova, G.; Ivanova, J.; Pilarski, P.; Chernev, G.; Chaneva, G. Effect of Heavy Metals on the Green Alga Scenedesmus Incrassatulus. Oxid. Commun. 2018, 41, 318–328. [Google Scholar]
- Sultana, N.; Hossain, S.M.; Mohammed, M.; Irfan, M.; Bashirul, H.; Faruque, M.O.; Abdur Razzak, S.; Hossain, M. Experimental Study and Parameters Optimization of Microalgae Based Heavy Metals Removal Process Using a Hybrid Response Surface Methodology-Crow Search Algorithm. Sci. Rep. 2020, 10, 15068. [Google Scholar] [CrossRef]
- François, R. Introduction à L’écotoxicologie: Fondements et Applications; Lavoisier: Cachan, France, 2007; ISBN 2-7430-1979-4. [Google Scholar]
- Nedjimi, B.; Beladel, B.; Guit, B. Biodiversity of Halophytic Vegetation in Chott Zehrez Lake of Djelfa (Algeria). Am. J. Plant Sci. 2012, 3, 1527–1534. [Google Scholar] [CrossRef]
- Koussa, M.; Bouziane, M. Apport Du SIG a La Cartographie Des Zones à Risque d’érosion Hydrique Dans La Région de Djelfa, Algérie. Leban. Sci. J. 2018, 19, 31–46. [Google Scholar] [CrossRef]
- Mouni, L.; Belkhiri, L.; Bouzaza, A.; Bollinger, J.-C. Chemical Associations and Sorption Capacity of Pb and Zn: Column Experiments on a Polluted Soil from the Amizour Mining District (Algeria). Environ. Earth Sci. 2016, 75, 96. [Google Scholar] [CrossRef]
- Pandey, G.; Sharma, M. Heavy Metals Causing Toxicity in Animals and Fishes. Res. J. Anim. Vet. Fish. Sci. 2014, 2, 17–23. [Google Scholar]
- Derakhshan, Z.; Faramarzian, M.; Mahvi, A.; Hosseini, M.S.; Miri, M. Assessment of Heavy Metals Residue in Edible Vegetables Distributed in Shiraz, Iran. J. Food Qual. Hazards Control 2016, 3, 25–29. [Google Scholar]
- Belkhiri, L.; Mouni, L. Geochemical Characterization of Surface Water and Groundwater in Soummam Basin, Algeria. Nat. Resour. Res. 2014, 23, 393–407. [Google Scholar] [CrossRef]
- Said, B.; Abderrahmane, B.; Mouni, L. Multivariate Statistical Analysis of the Groundwater of Ain Djacer Area (Eastern of Algeria). Arab. J. Geosci. 2016, 9, 248. [Google Scholar] [CrossRef]
- Priyadarshini, E.; Priyadarshini, S.; Pradhan, N. Heavy Metal Resistance in Algae and Its Application for Metal Nanoparticle Synthesis. Appl. Microbiol. Biotechnol. 2019, 103, 1–20. [Google Scholar] [CrossRef]
- Nouacer, I.; Benalia, M.; Henini, G.; Mebrouk, D.; Laidani, Y. Mathematical Modeling and Interpretation of Equilibrium Isotherms of Pb (II) from Aqueous Media by Chlorella Pyrenoidosa Immobilized in Luffa Cylindrica. Biomass Convers. Biorefinery 2021, 1–20. [Google Scholar] [CrossRef]
- Lotmani, B.; Mesnoua, M. Effects of Copper Stress on Antioxidative Enzymes, Chlorophyll and Protein Content in Atriplex Halimus. Afr. J. Biotechnol. 2011, 10, 10143–10148. [Google Scholar] [CrossRef]
- Balali-Mood, M.; Naseri, K.; Tahergorabi, Z.; Khazdair, M.; Sadeghi, M. Toxic Mechanisms of Five Heavy Metals: Mercury, Lead, Chromium, Cadmium, and Arsenic. Front. Pharmacol. 2021, 12, 643972. [Google Scholar] [CrossRef] [PubMed]
- Cavalletti, E.; Romano, G.; Palma Esposito, F.; Barra, L.; Chiaiese, P.; Balzano, S.; Sardo, A. Copper Effect on Microalgae: Toxicity and Bioremediation Strategies. Toxics 2022, 10, 527. [Google Scholar] [CrossRef] [PubMed]
- Laboratoire Environnement Ressources de Concarne. Qualité Du Milieu Marin Littoral. Bultin de la Surveillance, Edition 2008; Département du Finistè: Concarneau, France, 2008. [Google Scholar]
- Ater, M.; Ali, N.; Kasmi, H. Tolérance et Accumulation Du Cuivre et Du Chrome Chez Deux Espèces de Lentilles d’eau: Lemna Minor L. et Lemna Gibba L. Rev. des Sci. de l’eau 2006, 19, 57–67. [Google Scholar]
- Ah-Peng, C. Mise Au Point d’un Outil Diagnostic Basé Sur l’Utilisation de La Mousse Aquatique Fontinalis Antipyretica Hedw. En culture pour l’estimation de la qualité des cours d’eau. Ph.D. Thesis, Université de Lille II, Lille, France, 2003. [Google Scholar]
- Kaimoussi, A.; Mouzdahir, A.; Saih, A. Variations Saisonnières Des Teneurs En Métaux (Cd, Cu, Fe, Mn et Zn) Chez l’algue Ulva Lactuca Prélevée Au Niveau Du Littoral de La Ville d’El Jadida (Maroc). Comptes Rendus Biol. 2004, 327, 361–369. [Google Scholar] [CrossRef]
- Chafaa, M. Bio-Surveillance Des Métaux Lourds (Pb, Zn, Cu) à La Sortie de La Station d’épuration de Tiaret (Algérie) Au Moyen Des Végétaux Aquatiques: Plante Lemna Minor, Algue Spyrogyre Link Sp et Bryophyte Fontinalis Antipyretica. Ph.D. Thesis, Université Djilali Liabes, Sidi Bel Abbès, Algeria, 2015. [Google Scholar]
- Koehl, L.; Harp, J.; Han, D. Pb Neurotoxicity: Neuropsychological Effects of Lead Toxicity. BioMed Res. Int. 2014, 2014, 840547. [Google Scholar] [CrossRef]
- Kumar, V.; Abbas, A.K. Robbins y Cotran. Patología Estructural y Funcional; Elsevier Health Sciences: Amsterdam, The Netherlands, 2021; ISBN 84-13-82111-8. [Google Scholar]
- Kumar, S.; Sharma, A.; Kshetrimayum, C. Environmental & Occupational Exposure & Female Reproductive Dysfunction. Indian J. Med. Res. 2019, 150, 532. [Google Scholar]
- Zeghioud, H.; Assadi, A.A.; Khellaf, N.; Djelal, H.; Amrane, A.; Rtimi, S. Reactive species monitoring and their contribution for removal of textile effluent with photocatalysis under UV and visible lights: Dynamics and mechanism. J. Photochem. Photobiol. A Chem. 2018, 365, 94–102. [Google Scholar] [CrossRef]
- Ahmed Amine Azzaz, Salah Jellali, Hanene Akrout, Aymen Amine Assadi, Latifa Bousselmi, Dynamic investigations on cationic dye desorption from chemically modified lignocellulosic material using a low-cost eluent: Dye recovery and anodic oxidation efficiencies of the desorbed solutions. J. Clean. Prod. 2018, 201, 28–38.
- Zhuang, S.; Lu, X.; Yu, B.; Fan, X.; Yang, Y. Ascertaining the Pollution, Ecological Risk and Source of Metal(Loid)s in the Upstream Sediment of Danjiang River, China. Ecol. Indic. 2021, 125, 107502. [Google Scholar] [CrossRef]

| Cu (mg/kg) | Zn (mg/kg) | Fe (mg/kg) | Pb (mg/kg) | ||
|---|---|---|---|---|---|
| Values obtained in site 1 | Chara | 26 (±0.6) | 40 (±0.8) | 5600 (±3.7) | 48.1 |
| Zygnema | 30.5 (±0.3) | 39 (±0.5) | 1485 (±2.8) | 30.9 | |
| Cladophora | 82.5 (±0.4) | 44.5 (±0.9) | 2051 (±4.4) | 50.85 | |
| Spirogyra | 32.5 (±0.8) | 39 (±0.4) | 772.5 (±3.2) | 4.65 | |
| Values obtained in site 2 | Chara | 28.5 (±0.4) | 38.5 (±0.8) | 918 (±2.7) | 45.25 |
| Zygnema | 38.5 (±0.1) | 17.5 (±0.3) | 1490 (±3.9) | 34.75 | |
| Cladophora | 14.5 (±0.8) | 30 (±0.7) | 3030 (±3.4) | 40.55 | |
| Spirogyra | 13 (±0.7) | 36 (±0.7) | 1475 (±4.2) | 4.95 | |
| Norm Values obtained in site 3 | Chara | 27 (±0.2) | 39 (±0.9) | 1500 (±2.6) | 45.1 |
| Zygnema | 19.5 (±0.3) | 21 (±0.5) | 1335 (±3.4) | 16,4 | |
| Cladophora | 19 (±0.7) | 35.5 (±0.4) | 1565 (±5.3) | 3.15 | |
| Spirogyra | 52.5 (±0.6) | 47.5 (±0.3) | 2295 (±2.9) | 50.35 | |
| NOR Standards (AIEA, 2005) | Algae | 23.2 (±0.2) | 128 (±1.4) | 497 (±1.7) | 0.574 |
| F1 | F2 | F3 | F4 | |
|---|---|---|---|---|
| Own Value | 1.97 | 1.06 | 0.68 | 0.29 |
| Variability (%) | 49.26 | 26.46 | 17.02 | 7.26 |
| % Cumulative | 49.26 | 75.72 | 92.74 | 100.00 |
| Samples | Coordinates | Square Cosines | Contributions |
|---|---|---|---|
| Chara1 | 1.695 | 0.291 | 12.147 |
| Chara2 | 0.228 | 0.036 | 0.219 |
| Chara3 | 0.378 | 0.149 | 0.603 |
| Zygnema1 | 0.002 | 0.000 | 0.000 |
| Zygnema2 | −0.877 | 0.156 | 3.250 |
| Zygnema3 | −1.870 | 0.797 | 14.782 |
| Cladophora1 | 2.623 | 0.704 | 29.105 |
| Cladophora2 | −0.203 | 0.017 | 0.174 |
| Cladophora3 | −1.423 | 0.673 | 8.566 |
| Spirogyra1 | −1.018 | 0.320 | 4.382 |
| Spirogyra2 | −1.532 | 0.705 | 9.921 |
| Spirogyra3 | 1.996 | 0.905 | 16.852 |
Disclaimer/Publisher’s Note: The statements, opinions and data contained in all publications are solely those of the individual author(s) and contributor(s) and not of MDPI and/or the editor(s). MDPI and/or the editor(s) disclaim responsibility for any injury to people or property resulting from any ideas, methods, instructions or products referred to in the content. |
© 2023 by the authors. Licensee MDPI, Basel, Switzerland. This article is an open access article distributed under the terms and conditions of the Creative Commons Attribution (CC BY) license (https://creativecommons.org/licenses/by/4.0/).
Share and Cite
Dehbi, M.; Dehbi, F.; Kanjal, M.I.; Tahraoui, H.; Zamouche, M.; Amrane, A.; Assadi, A.A.; Hadadi, A.; Mouni, L. Analysis of Heavy Metal Contamination in Macroalgae from Surface Waters in Djelfa, Algeria. Water 2023, 15, 974. https://doi.org/10.3390/w15050974
Dehbi M, Dehbi F, Kanjal MI, Tahraoui H, Zamouche M, Amrane A, Assadi AA, Hadadi A, Mouni L. Analysis of Heavy Metal Contamination in Macroalgae from Surface Waters in Djelfa, Algeria. Water. 2023; 15(5):974. https://doi.org/10.3390/w15050974
Chicago/Turabian StyleDehbi, Meriem, Faouzia Dehbi, Muhammad Imran Kanjal, Hichem Tahraoui, Meriem Zamouche, Abdeltif Amrane, Aymen Amine Assadi, Amina Hadadi, and Lotfi Mouni. 2023. "Analysis of Heavy Metal Contamination in Macroalgae from Surface Waters in Djelfa, Algeria" Water 15, no. 5: 974. https://doi.org/10.3390/w15050974
APA StyleDehbi, M., Dehbi, F., Kanjal, M. I., Tahraoui, H., Zamouche, M., Amrane, A., Assadi, A. A., Hadadi, A., & Mouni, L. (2023). Analysis of Heavy Metal Contamination in Macroalgae from Surface Waters in Djelfa, Algeria. Water, 15(5), 974. https://doi.org/10.3390/w15050974

